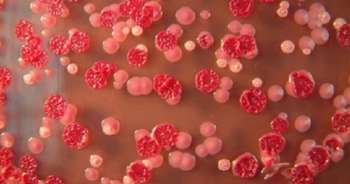
Nhiễm Whitmore nguy hiểm đến mức nào?

Nhiễm Whitmore nguy hiểm đến mức nào?
Trả lời báo chí, PGS TS Đỗ Duy Cường, Giám đốc Trung tâm Bệnh nhiệt đới, Bệnh viện Bạch Mai cho biết, chỉ trong tháng 8/2019, Trung tâm đã tiếp nhận 12 ca mắc Whitmore, trong đó có 4 ca đã tử vong. Căn bệnh truyền nhiễm nguy hiểm có tỷ lệ tử vong rất cao (từ 40-60%).